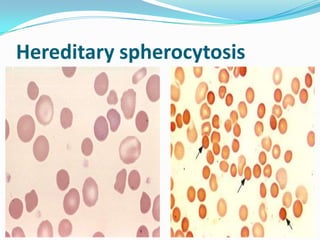
Hereditary spherocytosis
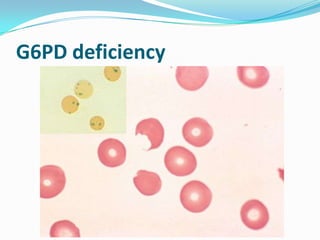
G6PD deficiency
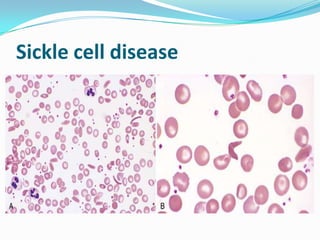
Sickle cell disease
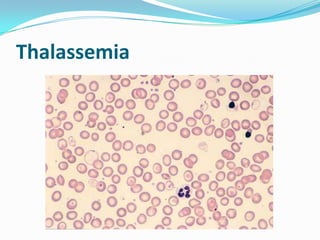
Thalassemia

This document summarizes hemolytic anemia, including its causes, characteristics, laboratory tests used for evaluation, and specific types like hereditary spherocytosis, hereditary elliptocytosis, G6PD deficiency, sickle cell disease, and thalassemia. Key tests discussed are serum bilirubin, urine urobilinogen, fecal stercobilinogen, serum haptoglobin, LDH, reticulocyte count, and the Coombs test for immunohemolytic anemia. Causes of hemolytic anemia include blood loss, increased red blood cell destruction (hemolysis), and increased red blood cell production.